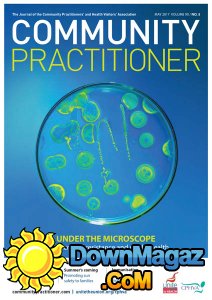
Community Practitioner - 05.2017

9-05-2017, 09:16
Community Practitioner, the monthly journal of Unite/Community Practitioners' and Health Visitors' Association. For health visitors, school nurses, community nursery nurses and all nurses in community and primary care settings
Health